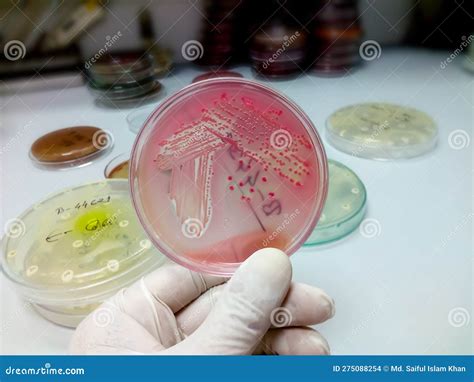

La seguridad de los productos cosméticos es una preocupación constante para las autoridades sanitarias y los consumidores. En este contexto, la Agencia Española de Medicamentos y Productos Sanitarios (AEMPS) juega un papel crucial en la vigilancia y control de los productos cosméticos que se comercializan en España. A través de informes, alertas y regulaciones, la AEMPS busca garantizar que los productos sean seguros para su uso y cumplan con la normativa vigente.
Durante el periodo de enero a marzo de 2024, se registraron 206 alertas de productos cosméticos. Estas alertas son de acceso público y se publican en la página web de la Comisión Europea.
Los peligrosos tóxicos en la industria cosmética
Sustancias Prohibidas y Restringidas
El Reglamento (CE) nº 1223/2009 sobre productos cosméticos establece una lista de sustancias prohibidas y restringidas en la fabricación de cosméticos. El anexo II de este reglamento enumera las sustancias que no pueden ser utilizadas en productos cosméticos, mientras que el anexo III detalla las sustancias que pueden ser utilizadas con restricciones específicas.
En este contexto, se han detectado varios productos cosméticos que contienen sustancias prohibidas, como el butilfenil metilpropional. Todos los productos cosméticos que han sido detectados en las alertas contienen butilfenil metilpropional, sustancia regulada en el anexo II - lista de sustancias prohibidas en productos cosméticos - del Reglamento (CE) nº 1223/2009, sobre productos cosméticos, con el número de orden 1666. La AEMPS ha contactado con las personas responsables en España para cesar la comercialización y retirar del mercado las unidades distribuidas de los productos.
Además, se modifica el anexo III para restringir el uso de la siguiente sustancia: hidroxiapatita.
Algunos productos también han sido señalados por contener concentraciones excesivas de sustancias restringidas, como el isoeugenol. Por ejemplo, se detectó un producto con una concentración excesiva de isoeugenol (valor medido: hasta 0,0052% en peso). Esta sustancia está regulada en el anexo III - lista de las sustancias que no podrán contener los productos cosméticos salvo con las restricciones establecidas - con el número de orden 73.

Riesgos Microbiológicos
Además de los riesgos químicos, también se han identificado riesgos microbiológicos en algunos productos cosméticos. La contaminación por bacterias puede causar infecciones e irritaciones, especialmente en personas con sistemas inmunológicos comprometidos o con piel dañada.
Se detectó la presencia de bacterias aerobias mesófilas, levaduras, mohos y la bacteria Burkholderia cepacia en un producto cosmético. La AEMPS informó del cese de comercialización, retirada del mercado y recuperación del lote 249999 del producto cosmético Serum firmeza, de la marca Nectar of bio - Les Cosmétiques Design Paris, por contaminación microbiológica.
Algunos ejemplos de riesgos microbiológicos detectados incluyen:
- Producto contaminado con bacterias mesofílicas aeróbicas (Burkholderia cepacia), que pueden causar infecciones de heridas, neumonía y sepsis, especialmente en personas inmunocomprometidas.
- Producto microbiológicamente contaminado con la bacteria Klebsiella Pneumoniae, lo que plantea un riesgo de infección para el usuario.
- Producto contaminado microbiológicamente con bacterias mesófilas aeróbicas (valor medido hasta 9200 cfu/g). Si se usa en la piel dañada, o si entra en contacto con los ojos, el producto puede causar infección o irritación.
En algunos casos, se han detectado productos con contaminación tanto química como microbiológica. Por ejemplo, un producto contenía una cantidad excesiva de 2-fenoxietanol (valor medido: 1,7 %), superando la concentración máxima permitida del 1,0 %. Además, estaba contaminado microbiológicamente con bacterias mesófilas (valores medidos 490 UFC/g/ml). Si se usa en la piel dañada, o si entra en contacto con los ojos, el producto puede causar infección o irritación.
Otras Alertas y Medidas
Además de las alertas relacionadas con sustancias prohibidas y riesgos microbiológicos, también se han emitido alertas por concentraciones excesivas de sustancias como el peróxido de hidrógeno en productos blanqueadores. Se detectaron productos con concentraciones de 6,9 % y 2,5 % de peróxido de hidrógeno, superando el límite máximo permitido de 0,1 % para productos de uso general.
La AEMPS ha transmitido las medidas comunicadas mediante estas alertas a las comunidades autónomas para su seguimiento. Estas medidas incluyen la retirada del producto del mercado y el cese de comercialización.
En cuanto a los productos relacionados a continuación, la autoridad notificante en RAPEX ha incluido a España entre los posibles países de destino.
Nueva Funcionalidad en la Aplicación CERTCOS_CLV
La AEMPS también ha implementado mejoras para facilitar la gestión de certificados de libre venta a las empresas exportadoras de cosméticos. La AEMPS informó a través de la nota informativa COS, 03/2024 de una nueva función en la aplicación CERTCOS_CLV, disponible en la sede electrónica de la AEMPS. Esta nueva función permite agrupar en un mismo certificado hasta cuatro solicitudes e incluir hasta un máximo de 100 productos cosméticos para un mismo país. El objetivo de esta actualización es facilitar la gestión de los certificados de libre venta a las empresas exportadoras de cosméticos.
Cosmetovigilancia
La AEMPS también publicó la nota informativa COS, 04/2024 para informar del aumento en un 130% de las notificaciones de efectos no deseados de cosméticos en 2023. Este aumento en el número de casos recibidos tiene un gran valor para la cosmetovigilancia, que desde el año 2020 seguía una tendencia descendente.
Este informe recoge los casos de efectos no deseados relacionados con el uso de productos cosméticos ocurridos en España, que fueron registrados por la AEMPS entre el 1 de enero de 2023 y el 31 de diciembre de 2023. También recoge los casos graves que han tenido lugar en otros Estados miembros de la Unión Europea y que han sido comunicados a la AEMPS.

Tabla Resumen de Riesgos y Sustancias
| Tipo de Riesgo | Sustancia o Agente | Regulación | Posibles Efectos |
|---|---|---|---|
| Químico | Butilfenil Metilpropional | Anexo II del Reglamento (CE) nº 1223/2009 | Desconocidos (prohibido en cosméticos) |
| Químico | Isoeugenol (exceso) | Anexo III del Reglamento (CE) nº 1223/2009 | Irritación |
| Microbiológico | Burkholderia cepacia | N/A | Infecciones de heridas, neumonía, sepsis |
| Microbiológico | Klebsiella Pneumoniae | N/A | Infección |
| Químico y Microbiológico | 2-Fenoxietanol (exceso) y Bacterias Mesófilas | Anexo V del Reglamento (CE) nº 1223/2009 (2-Fenoxietanol) | Infección o irritación |
| Químico | Peróxido de Hidrógeno (exceso) | Anexo III del Reglamento (CE) nº 1223/2009 | Irritación, daño en la piel |